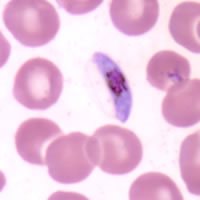
P. falciparum gametocyte - thin smear
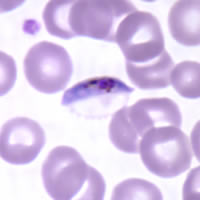
P. falciparum gametocyte - thin smear

|
|
[Last Modified: ] |
|
|
|
| [Plasmodium
falciparum] [Plasmodium malariae] [Plasmodium ovale] [Plasmodium vivax] |
Plasmodium falciparum: Gametocytes
 |
Figs. 27, 28:
Mature macrogametocytes (female); Figs. 29, 30: Mature microgametocytes (male).
Illustration from:
Coatney GR, Collins WE, Warren M, Contacos PG. The Primate Malarias. Bethesda:
U.S. Department of Health, Education and Welfare; 1971.
Smears from patients:
Plasmodium falciparum gametocytes, when mature are crescent or sausage shape. The red blood cell is often distorted or not visible.
 |
 |
| A | B |
|
|
| C | D |
A, B, C, D: Gametocytes of P. falciparum in thin blood smears. Note the presence of a “Laveran’s bib," which is not always visible.
 |
| E |
E: Two gametocytes captured from a thick blood smear.
|
|||